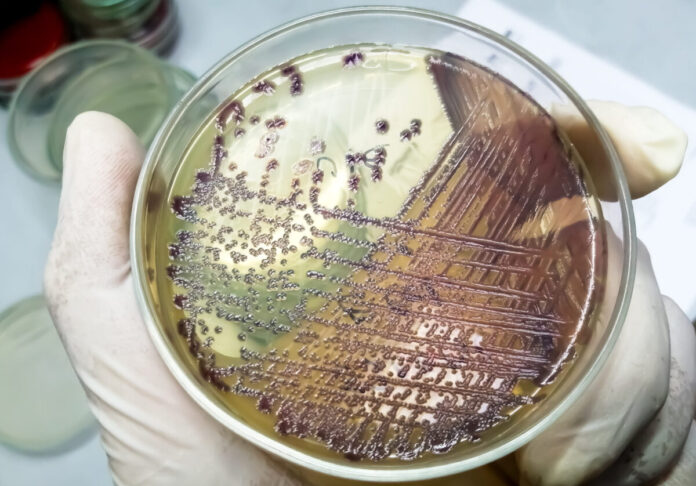

Evaluating the quality of day-old chicks (DOC) is crucial for successful poultry production. This practical guide outlines the key physical indicators, health factors, and laboratory testing protocols necessary for hatchery managers, veterinarians, and poultry professionals to ensure optimal chick performance. It incorporates recognized standards for Ross 308 and Cobb 500 commercial breeds, and highlights the importance of diagnostic methods such as PCR, ELISA, and microbiological testing. Together, these measures serve as a comprehensive framework for improving flock uniformity, reducing mortality, and preventing disease outbreaks.
Introduction
The foundation of profitable poultry farming lies in the quality of day-old chicks. Both physical characteristics and health status determine early growth, feed efficiency, and survival. This guide presents practical methods to evaluate chick quality, integrate health monitoring, and apply laboratory diagnostics, helping poultry professionals maintain high standards throughout production.

Importance of day-old chicks physical inspection
Visual and physical inspection of day-old chicks in hatcheries is a critical step to ensure chick quality and flock performance. This process involves assessing external features such as chick appearance, feathering, navel closure, leg condition, and overall vitality. Healthy chicks should be alert, active, free from deformities, and have clean, dry plumage with a well-healed navel. Identifying and removing weak, dehydrated, or abnormal chicks at this stage reduces early mortality and promotes uniform growth in the flock. Such inspections are essential for maintaining hatchery standards and improving production outcomes.

Maintaining a disease-free status is essential for chick vitality and growth. Viral and bacterial diseases commonly affect day-old chicks and must be monitored.

The role of laboratory testing in quality control of day-old chicks

Laboratory testing plays a vital role in hatchery quality control, ensuring the health and uniformity of day-old chicks. Among the most important diagnostic tools, the enzyme-linked immunosorbent assay (ELISA) is widely used to evaluate maternal antibody transfer and immune status against critical pathogens such as Newcastle disease virus (NDV), infectious bursal disease virus (IBDV), avian influenza virus (AIV), Mycoplasma gallisepticum (MG), Mycoplasma synoviae (MS), and Salmonella spp. Accurate ELISA results provide insights into breeder vaccination effectiveness and biosecurity performance. Additionally, detecting positive ELISA results or PCR confirmation for Mycoplasma and Salmonella in day-old chicks indicates vertical transmission, signaling serious management failures that can lead to early chick mortality and economic losses. Therefore, integrating serological, molecular, and microbiological testing into hatchery and breeder flock protocols is essential to maintain high-quality chicks, reduce disease risk, and optimize flock performance.

Additional quality factors
- Yolk sac absorption: residual yolk should be less than 10% of body weight for optimal immunity and energy.
- Internal organ health: liver, heart, and intestines should be well-developed and free of lesions.
- Environmental management: proper incubation tempe-rature, humidity, egg storage, and early feeding improve chick quality.
- Biosecurity: strict hygiene protocols reduce disease risk and improve hatchery output.
References
Aviagen. (2022). Ross broiler management handbook. Huntsville, AL: Aviagen Group.
BioChek. (2021). Practical guide to serology in poultry. Reeuwijk, The Netherlands: BioChek UK Ltd.
Cobb-Vantress. (2022). Cobb 500 broiler management guide. Siloam Springs, AR: Cobb-Vantress, Inc.
Decuypere, E., & Bruggeman, V. (2007). The endocrine interface of environmental and egg factors affecting chick quality. Poultry Science, 86(5), 1037–1042. https://doi.org/10.1093/ps/86.5.1037
EFSA Panel on Biological Hazards (BIOHAZ). (2021). Salmonella control in poultry flocks. EFSA Journal, 19(4), e06573. https://doi.org/10.2903/j.efsa.2021.6573
Fasenko, G. M. (2007). Egg storage and the embryo. Poultry Science, 86(5), 1020–1024. https://doi.org/10.1093/ps/86.5.1020
Glisson, J. R., Hofacre, C. L., & McDougald, L. R. (2013). Mycoplasma gallisepticum and Mycoplasma synoviae infections. In Y. M. Saif, H. J. Barnes, J. R. Glisson, A. M. Fadly, L. R. McDougald, & D. E. Swayne (Eds.), Diseases of poultry (13th ed., pp. 877–893). Wiley-Blackwell.
IDEXX Laboratories. (2021). ELISA testing guide for poultry health. Westbrook, ME: IDEXX Laboratories.
North, M. O., & Bell, D. D. (1990). Commercial chicken production manual (4th ed.). New York: Van Nostrand Reinhold.
Swayne, D. E. (Ed.). (2013). Avian influenza (2nd ed.). Wiley-Blackwell.
Swayne, D. E. (Ed.). (2020). Diseases of poultry (14th ed.). Wiley-Blackwell.
Tona, K., Onagbesan, O., Bruggeman, V., & Decuypere, E. (2004). Effects of age of broiler breeders and egg storage on egg quality, hatchability, chick quality, chick weight, and posthatch growth to forty-two days. Poultry Science, 83(5), 736–743. https://doi.org/10.1093/ps/83.5.736















